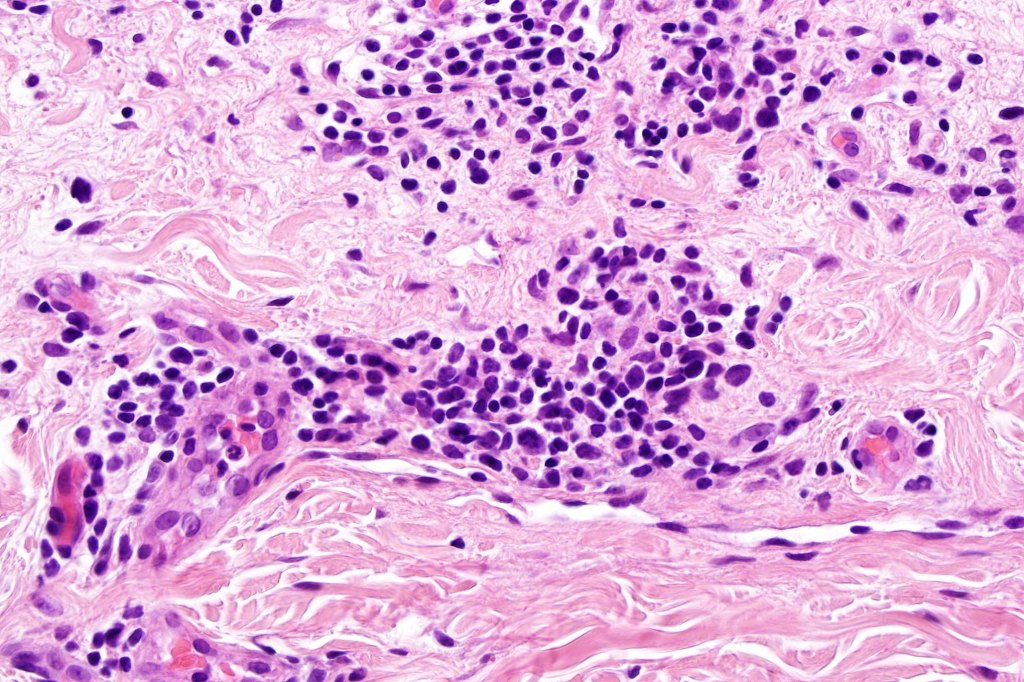
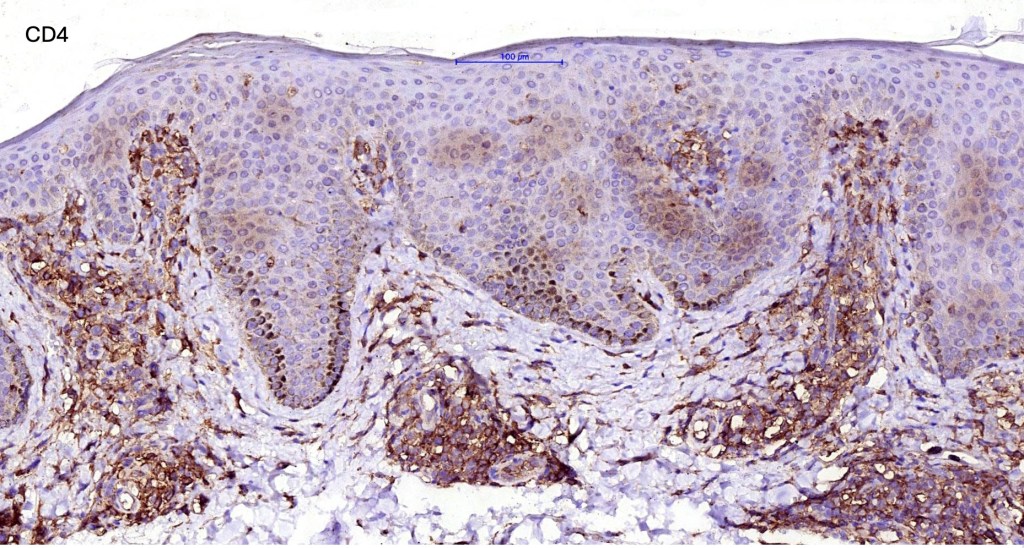

Definition
•Leukemic variant of CTCL with a very poor prognosis
•Erythroderma affecting 80% or more of the integument; often scaly, intensely pruritic; sometimes marked edema
•Lymphadenopathy
•Circulating Sézary cell count of >1000/sq mm.
•CD4:CD8 of 10 or more
• CD4+/CD7- of 40% or more
•CD4+ve/CD26-ve of 30% or more
•Variable loss of T-cell antigens
•T-cell monoclonal population in skin, lymph nodes & peripheral blood
Clinical features
•M>F; 2 Black:1White populations
•Additional features may include non-scarring alopecia, ectropion, nail dystrophy & palmoplantar keratoderma, lymphadeopathy, hepatosplenomegaly
.Staging see mycosis fungoides blog

Histological features
•Variable histological features ranging from a non-specific superficial perivascular or band-like dermal infiltrate with minimal or no epidermotropism through to mycosis fungoides-like histology; can mimic atopic dermatitis
•Sézary cells are CD45RO, CLA, CD158 & CD4+
.Loss of CD7 (40% or more) & CD26 (30% or more)
•Variable loss of CD2, CD3 & CD5
•Exceptional CD4-/CD8+ & CD4+/CD8+ variants
.Clonal TCR

Leave a comment